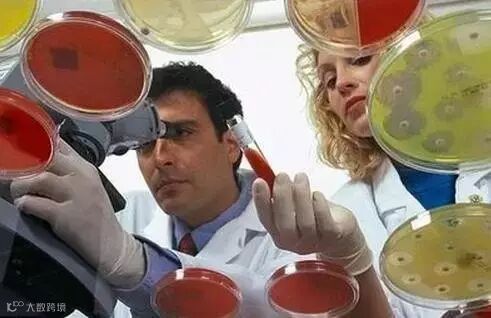

在汉堡峰会上,G20成员国一致决定,开展全球抗生素耐药性研究计划,为此,德国联邦教研部宣布提供5亿欧元,支持这项为期10年的研究。
德国联邦教研部部长万卡表示:“20国集团将采取联合行动,研究相应的解决方案,以应对紧迫的全球性挑战,并为国际社会未来应对卫生突发事件做好准备。”G20成员国将建立一个共同的合作平台,加强抗生素耐药性的研发,并加强成员国之间的信息沟通。该计划对所有成员国机构,包括非政府团体开放。作为今年G20峰会主席国,德国将在今年秋季着手这项平台的筹建工作。
在G20峰会之前的成员国卫生部长会议上,各国还就开展抗微生物耐药性计划 (JPIAMR)和建立全球抗生素研发伙伴关系(GARDP)等一些重要措施达成一致意见。万卡表示,只有国际社会共同参与,才能解决耐药菌带来的全球性挑战。作为这项国际合作计划的倡导成员,德国在2017年1月已发起建立“流行病防御创新联盟”(简称CEPI),由多个政府和民间基金会与受到流行病影响的国家一起开发防病毒疫苗,控制流行病传播。促成CEPI成立的动因是,2014年暴发的埃博拉病毒直接导致了1.1万人死亡。德国联邦教研部决定,今后5年将为CEPI提供9000万欧元的疫苗研发费用。
德国政府在国家层面也积极推动控制传染病,德国联邦议会2017年4月通过了联邦教研部提出的两项配套措施——关于替代药物和快速诊断技术创新的紧急资助,为新药和新医疗产品工业化提供帮助。(本文原题为《G20启动国际抗生素耐药性研发计划》)摘自《中国生物技术信息网》http://www.biotech.org.cn
● 中国科学院上海生命科学研究院——贵安新区生物医学大数据中心揭牌

巴傲得生物|身边的科研顾问
微信ID:zhjvn-Bioworld

长按二维码关注我们



